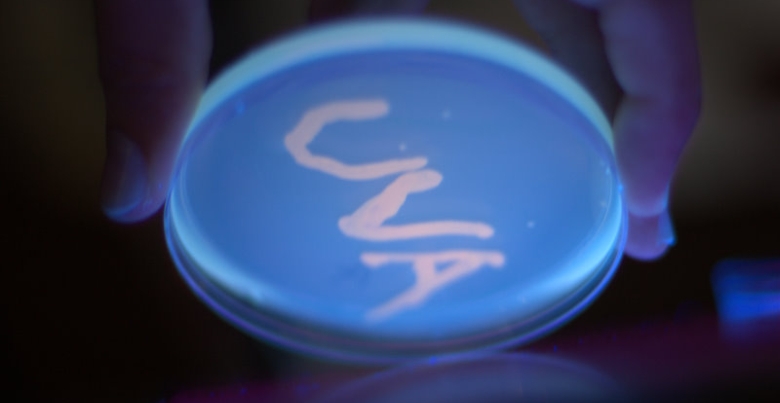

CHE.496/2009/Schedule/Oral presentations of part design/Group 2
From OpenWetWare
Jump to navigationJump to search
Group 2
- Members: Rohini & Maria
http://openwetware.org/images/4/44/Biobrickproject_MariaFini_RohiniManaktala.pdf
http://www.pnas.org/content/90/4/1212.full.pdf